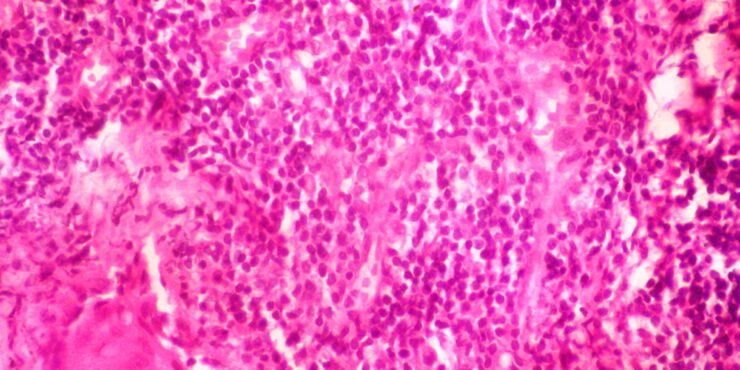
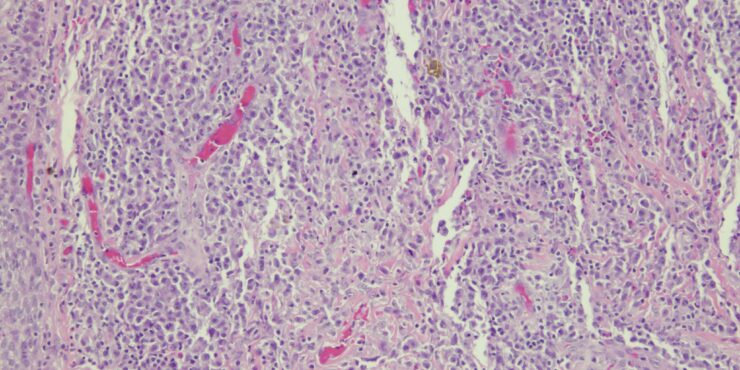

Lupus vulgaris = الذأب الشائع
Lupus vulgaris = الذأب الشائع Lupus Vulgaris LV is an extremely chronic, progressive form of cutaneous tuberculosis occurring in individuals with moderate immunity and a high degree of tuberculin sensitivity. Differential Diagnosis of Tuberculosis Verrucosa Cutis · Warts or keratoses · Hyperkeratotic lupus vulgaris · Blastomycosis · Chromomycosis · Bromoderma · Lesions due to […]
Read More